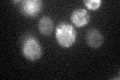
YHR038W
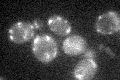
YHR038W
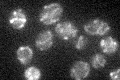
YHR038W

View description
Mitochondrial ribosome recycling factor, essential for mitochondrial protein synthesis and for the maintenance of the respiratory function of mitochondria
Localization:
Intensity:
Fold change:
Significance:
-
C’ GFP library in SD

mitochondria23.73 -
N' NOP1pr-GFP in SD

mitochondria69.4231 -
N' TEF2pr-mCherry in SD

mitochondriaN/A -
N' NATIVEpr-GFP in SD

mitochondria19.6854 -
N' TEF2pr-VC and Cyto-VN in SD

#N/A0 -
C’ GFP library in SD+DTT
mitochondria19.610.82No -
C’ GFP library in SD+H2O2
mitochondria17.920.75Yes -
C’ GFP library in Starvation Media
mitochondria30.861.3No -
C’ GFP library on the background of Pup2-DaMP

mitochondria -
C’ GFP library on the background of CCT mutant

mitochondria28.92121.21849No
